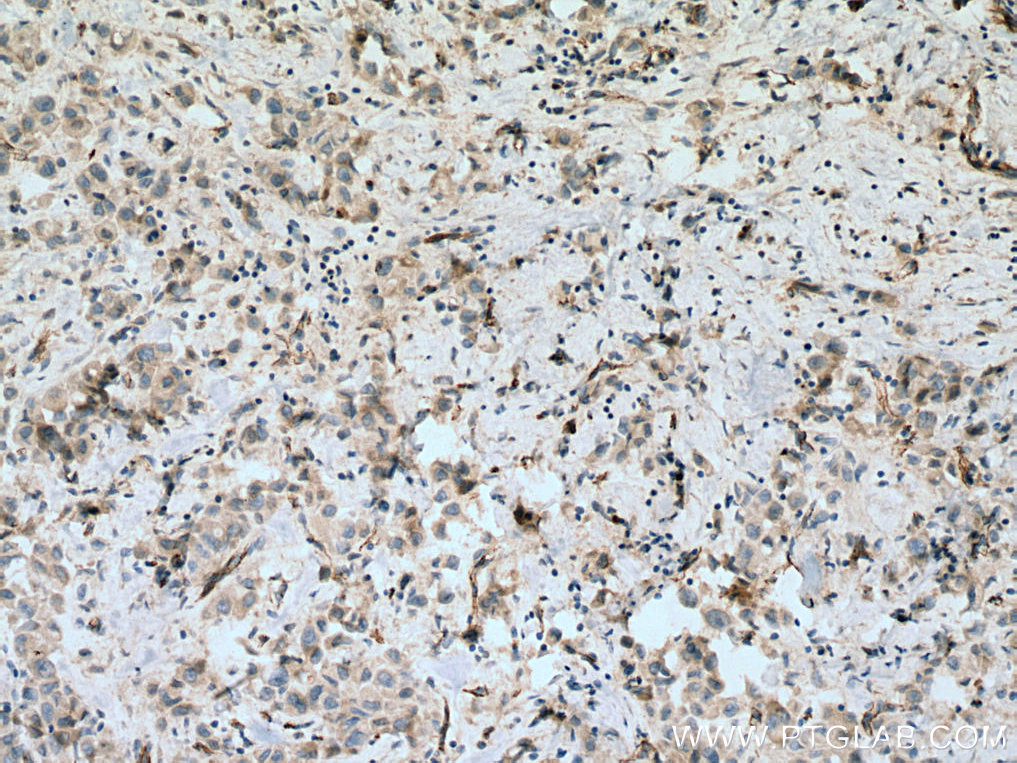

验证数据展示
经过测试的应用
| Positive WB detected in | HUVEC cells, human placenta tissue |
| Positive IHC detected in | human placenta tissue, human breast cancer tissue, human lung cancer tissue Note: suggested antigen retrieval with TE buffer pH 9.0; (*) Alternatively, antigen retrieval may be performed with citrate buffer pH 6.0 |
| Positive IF/ICC detected in | HUVEC cells |
| Positive FC detected in | HUVEC cells |
推荐稀释比
| 应用 | 推荐稀释比 |
|---|---|
| Western Blot (WB) | WB : 1:1000-1:4000 |
| Immunohistochemistry (IHC) | IHC : 1:500-1:2000 |
| Immunofluorescence (IF)/ICC | IF/ICC : 1:50-1:500 |
| Flow Cytometry (FC) | FC : 0.40 ug per 10^6 cells in a 100 µl suspension |
| It is recommended that this reagent should be titrated in each testing system to obtain optimal results. | |
| Sample-dependent, Check data in validation data gallery. | |
产品信息
27956-1-AP targets VE-cadherin/CD144 in WB, IHC, IF/ICC, FC, ELISA applications and shows reactivity with human samples.
| 经测试应用 | WB, IHC, IF/ICC, FC, ELISA Application Description |
| 文献引用应用 | WB, IHC, IF |
| 经测试反应性 | human |
| 文献引用反应性 | human |
| 免疫原 |
CatNo: Ag27487 Product name: Recombinant human CDH5 protein Source: e coli.-derived, PGEX-4T Tag: GST Domain: 54-241 aa of NM_001795 Sequence: MHIDEEKNTSLPHHVGKIKSSVSRKNAKYLLKGEYVGKVFRVDAETGDVFAIERLDRENISEYHLTAVIVDKDTGENLETPSSFTIKVHDVNDNWPVFTHRLFNASVPESSAVGTSVISVTAVDADDPTVGDHASVMYQILKGKEYFAIDNSGRIITITKSLDREKQARYEIVVEARDAQGLRGDSGT 种属同源性预测 |
| 宿主/亚型 | Rabbit / IgG |
| 抗体类别 | Polyclonal |
| 产品类型 | Antibody |
| 全称 | cadherin 5, type 2 (vascular endothelium) |
| 别名 | VE-cadherin, 7B4, 7B4 antigen, Cadherin 5, Cadherin-5 |
| 计算分子量 | 88 kDa |
| 观测分子量 | 120-140 kDa |
| GenBank蛋白编号 | NM_001795 |
| 基因名称 | VE-cadherin |
| Gene ID (NCBI) | 1003 |
| RRID | AB_2918136 |
| 偶联类型 | Unconjugated |
| 形式 | Liquid |
| 纯化方式 | Antigen affinity purification |
| UNIPROT ID | P33151 |
| 储存缓冲液 | PBS with 0.02% sodium azide and 50% glycerol, pH 7.3. |
| 储存条件 | Store at -20°C. Stable for one year after shipment. Aliquoting is unnecessary for -20oC storage. |
背景介绍
Cadherins are a family of transmembrane glycoproteins that mediate calcium-dependent cell-cell adhesion and play an important role in the maintenance of normal tissue architecture. Vascular endothelial cadherin (VE-cadherin), also known as Cadherin-5 (CDH5) or CD144, is a member of the type II classical cadherin family of cell adhesion proteins (PMID: 21269602). VE-cadherin is expressed specifically in endothelial cells and mediates homophilic adhesion in the vascular endothelium (PMID: 1522121; 8555485; 21269602). VE-cadherin plays a role in the organization of lateral endothelial junctions and in the control of permeability properties of vascular endothelium (PMID: 1522121). VE-cadherin has also been shown to be required for angiogenesis (PMID: 16473763; 18162609). The calculated molecular weight of VE-cadherin is 88 kDa and the apparent molecular weight of 120-140 kDa is higher due to post-translational glycosylation and phosphorylation (PMID: 10460833; 29894844). Full-length VE-cadherin can be proteolytically cleaved to generate a fragment of 90-100 kDa (PMID: 9786462; 22064597).
实验方案
| Product Specific Protocols | |
|---|---|
| FC protocol for VE-cadherin/CD144 antibody 27956-1-AP | Download protocol |
| IF protocol for VE-cadherin/CD144 antibody 27956-1-AP | Download protocol |
| IHC protocol for VE-cadherin/CD144 antibody 27956-1-AP | Download protocol |
| WB protocol for VE-cadherin/CD144 antibody 27956-1-AP | Download protocol |
| Standard Protocols | |
|---|---|
| Click here to view our Standard Protocols |
发表文章
| Species | Application | Title |
|---|---|---|
Nat Commun FNIP1 abrogation promotes functional revascularization of ischemic skeletal muscle by driving macrophage recruitment | ||
Adv Healthc Mater Colon-Targeted Ginseng Polysaccharides-Based Microspheres for Improving Ulcerative Colitis via Anti-Inflammation and Gut Microbiota Modulation | ||
Bioengineering (Basel) Organotypic 3D Co-Culture of Human Pleura as a Novel In Vitro Model of Staphylococcus aureus Infection and Biofilm Development | ||
Pharmaceuticals (Basel) CXCL8 Promotes Endothelial-to-Mesenchymal Transition of Endothelial Cells and Protects Cells from Erastin-Induced Ferroptosis via CXCR2-Mediated Activation of the NF-κB Signaling Pathway | ||
World J Diabetes Tongxinluo promotes endothelium-dependent arteriogenesis to attenuate diabetic peripheral arterial disease | ||
Front Cell Infect Microbiol Analysis of miRNAs Involved in Mouse Heart Injury Upon Coxsackievirus A2 Infection. |